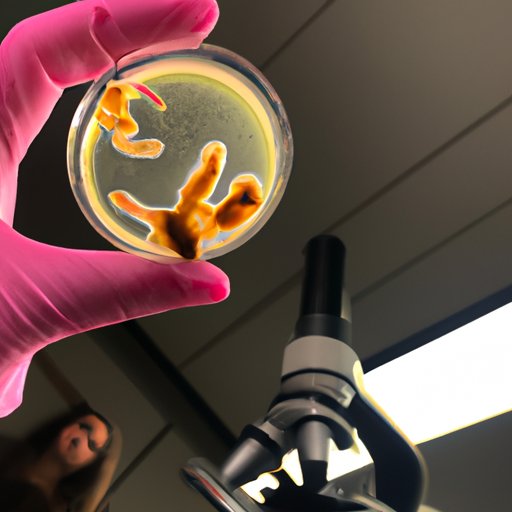

Introduction
The question of when life begins has long been a source of controversy and debate across various disciplines, from the legal and ethical to the religious and philosophical. But what does science have to say about this contentious issue? In this article, we’ll explore the answer to this question by examining the legal and ethical implications of when life begins according to science, the biological evidence for when life begins, and the religious and philosophical perspectives on the same. We’ll also provide an overview of the scientific research on when life begins.

Examining the Legal and Ethical Implications of When Life Begins According to Science
When it comes to the legal and ethical implications of when life begins, there are a variety of different perspectives. For example, in the United States, the Supreme Court has ruled that the right to abortion is protected under the Fourteenth Amendment. This means that women have the right to make decisions regarding their own bodies, including the decision to terminate a pregnancy. However, many states have passed laws that restrict or even criminalize certain abortion procedures, which can be seen as conflicting with the Supreme Court’s ruling.
From an ethical perspective, many people believe that life begins at conception, and thus any form of abortion should be considered murder. Others argue that life does not begin until the fetus becomes viable outside the womb, or until birth, and thus abortion should be allowed up until those points. Ultimately, both sides of the debate have valid arguments, and the answer to this question ultimately depends on one’s personal beliefs.
Exploring the Biological Evidence for When Life Begins
In terms of biological evidence, scientists have conducted numerous studies to determine when life begins. One study, published in the journal Human Reproduction, found that human embryos begin to develop after just three days of fertilization. This suggests that life begins at conception, but other studies have suggested that life does not begin until the fetus is viable outside the womb, or until birth.
In addition, advances in technology have allowed scientists to detect signs of life in fetuses much earlier than ever before. For example, researchers have used ultrasounds and MRI scans to detect fetal heartbeats as early as six weeks into a pregnancy. This has led some to argue that life begins much earlier than previously thought, while others maintain that life does not begin until birth.

Debating the Religious and Philosophical Perspectives on When Life Begins
The religious and philosophical perspectives on when life begins vary greatly depending on the religion or philosophy in question. For example, some religions, such as Christianity, believe that life begins at conception and thus view abortion as a sin. Other religions, such as Buddhism, do not have a clear stance on when life begins and instead leave it up to individuals to decide.
Similarly, philosophers have debated the issue of when life begins for centuries. Some philosophers, such as Immanuel Kant, have argued that life begins at conception, while others, such as John Locke, have argued that life does not begin until birth. Ultimately, each individual must decide for themselves when life begins based on their own beliefs and values.
An Overview of the Scientific Research on When Life Begins
Although the legal, ethical, religious, and philosophical perspectives on when life begins can vary greatly, the scientific evidence suggests that life begins at conception. Numerous studies have shown that human embryos begin to develop within days of fertilization, and advances in technology have enabled scientists to detect signs of life in fetuses much earlier than ever before. This suggests that life begins much earlier than previously thought.
However, the impact of science on the definition of when life begins is still being debated. Some argue that science should not be used to dictate when life begins, while others believe that it should be taken into consideration when making decisions about abortion and other related issues. Ultimately, the answer to this question will depend on the individual.
Conclusion
In conclusion, the question of when life begins is a complex one that has been debated for centuries. While the legal, ethical, religious, and philosophical perspectives on when life begins vary greatly, the scientific evidence suggests that life begins at conception. This has implications for how we view abortion and other related issues, and it is ultimately up to individuals to decide for themselves when life begins based on their own beliefs and values.
(Note: Is this article not meeting your expectations? Do you have knowledge or insights to share? Unlock new opportunities and expand your reach by joining our authors team. Click Registration to join us and share your expertise with our readers.)